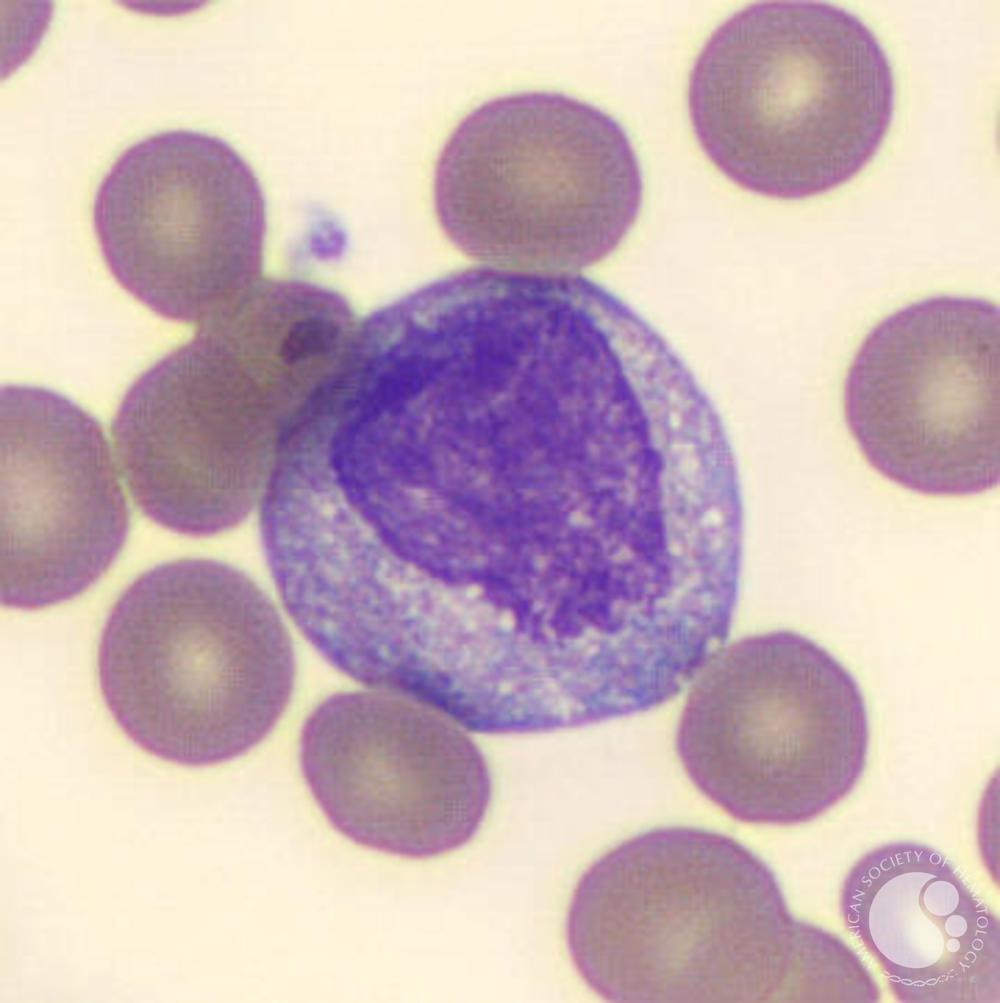
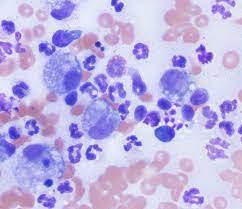
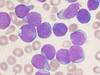

Bone Marrow Evaluation
Reason For
Peripheral blood differential counts abnormal
* persistent pancytopenia, neutropenia, or thrombocytopenia unexplained
* non-regenerative anemia
* abnormal morphology
* immature cells for no reason
* staging for neoplasia
* parasitic infections
Bone Marrow Collection Sites
- Head of humerus
- Femoral head
- Can use illium, but not as common
Aspiration Biopsy
(BM)
- Gathers fluid portion of bone marrow and cells
- Morphology easier to read than core biopsy
- Small amount collected and placed in dilute EDTA immediately ; smear made
Core Biopsy
Core piece of bone marrow
* better sample
* greater diagnostic info
* shows tissue relationship
* better cellularity (no blood dilution)
* parasites easier to see
Preparing Bone Marrow Smear
- Make immediately if not mixed with EDTA
- If mixed, make within an hour
- Samples will be thicker and have spicules (areas that contain cells)
- Use line, starfish, or compression
Reading Bone Marrow Smears
- Do peripheral blood smear at same time
- Start on Low Power - gives overall cellularity
- Fat does not stain (will look like vacuoles)
- High Power gives M:E ratio
Low Power BM Exam
Acellular vs Hypercellular vs Hypocellular
Look for megakaryocytes
* may be at edge of slide
* 2-10 /LPF normal
* not evenly distributed
* determines if platelets are normal or not
Cellularity by Age
Fat vs Nucleated Cells
Adults
* 50% nucleated, 50% fat
Young
* 75% nucleated, 25% fat
Old
* 25% nucleated, 75% fat
Define
BM Hypoplasia
Decreased number of cells
* <25% cellularity
* large areas of fat
High Power BM Exam
- Percentage of erythroid and myeloid cells (M:E ratio)
- Evalutes for hemosiderin
- Describe morphology
M:E Ratio
Classify 500 cells
* erythroid: 80-90% rubricytes and metarubricytes
* myeloid: 80-90% metamyelocytes, bands, and segs
Normal = 0.75:1 and 2:1 (use 1:1 for class)
Erythroid Series
Characteristics
- Darker basophilic blue cytoplasm
- Circular nucleus

Rubriblast
* RBC series
* most immature
* large cell with large nucleus
* multiple nucleoli
* basophilic cytoplasm
* possible mitotic figures

Prorubricyte
* RBC series
* 2nd in series
* nuclear material dense and clumped
* basophilic cytoplasm

Rubricyte
* RBC series
* 3rd in line
* hemoglobin being produced
* polychromatophilic
* blue/pink cytoplasm

Metarubricyte
* RBC series
* also called nRBCs
Myeloid Series
- Lighter lavender color cytoplasm
- Nucleus amoeboid shape

Myeloblasts
* WBC steries
* most immature
* multiple nucleoli
* large nucleus
* scant cytoplasm

Promyelocyte
* WBC series
* 2nd in line
* large nucleus
* nucleoli may be present
* pink/red granules noted
Myelocyte
* WBC series
* 3rd in line
* greater nucleus-to-cytoplasm ratio
* granules throughout cytoplasm
* where distinction of E, N, B

Metamyelocyte
* granules present in cytoplasm
* nucleus indented or “kidney-bean” shape
* nucleus smaller than before
* cytoplasm a lighter blue

Megakaryocyte
* platelet series
* multiple condensed nuclei
* large size
* not counted in M:E ratio
Classify Aspirate
Inflammatory Leukogram
* almost all cells are myeloid precursors and neutrophils
Order of Maturation
There should be 1 blast cell for every 16-32 mature cells